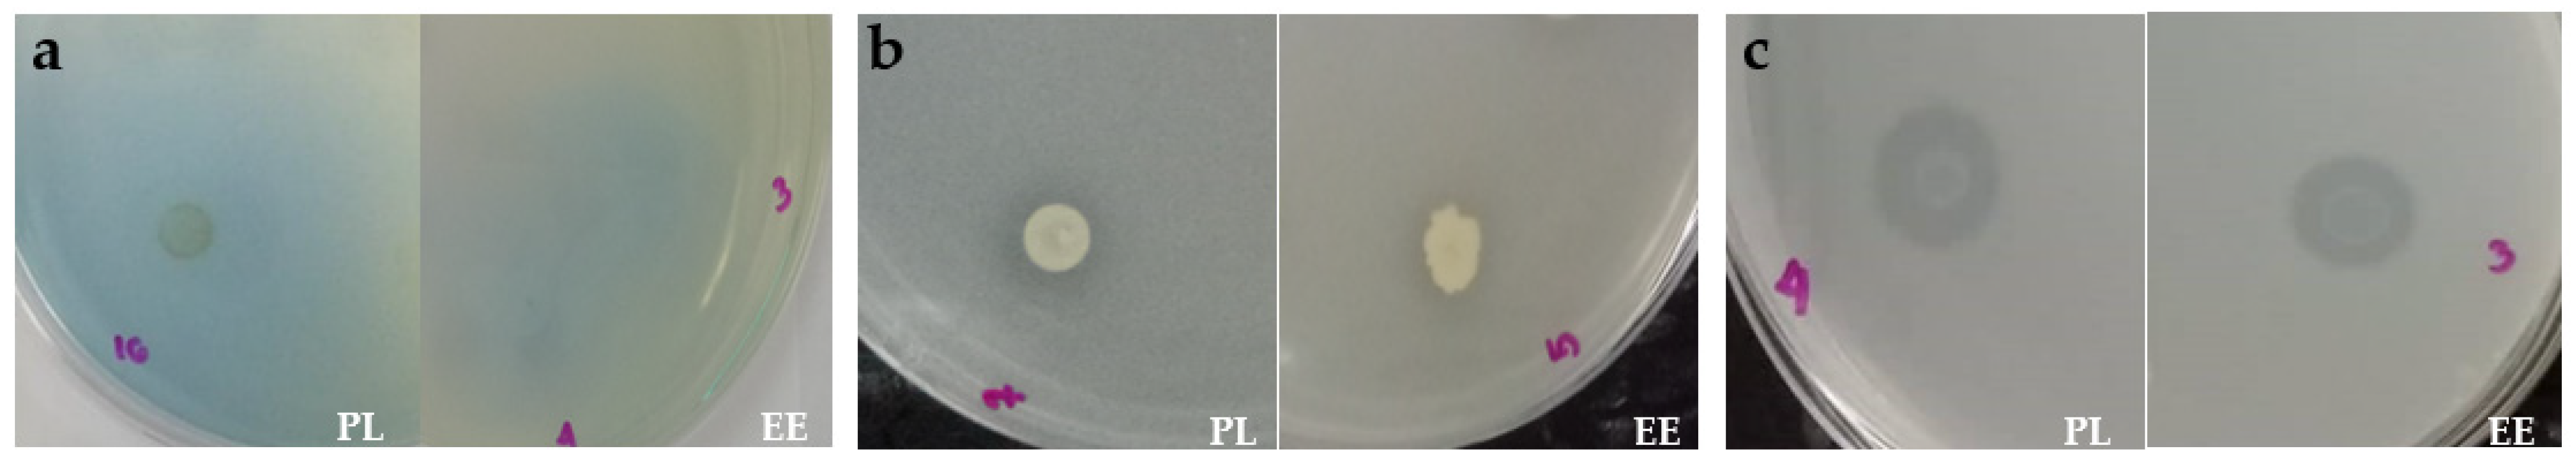
Applsci 13 10364 g009

Vermicast Analysis with the Earthworm Species Pheretima losbanosensis (Crassiclitellata: Megascolecidae): Bacterial Profiles for Potential Applications in Agriculture
Abstract
:1. Introduction
2. Materials and Methods
2.1. Collection of Earthworm Samples
2.2. Earthworm Species Morphological Diagnosis
2.2.1. Eudrilus Eugeniae
2.2.2. Pheretima losbanosensis
2.3. DNA Extraction and Next-Generation Sequencing
2.4. Community-Level Physiological Profiling (CLPP) of Bacteria in Vermicasts
2.5. Bacterial Isolation from Vermicasts
2.6. Bacterial Nutrient Mineralization Screening
3. Results and Discussion
3.1. Bacterial Community Profile of Vermicasts
3.2. Physiological Profiles of Bacteria in Vermicasts
3.3. Nutrient Mineralization Activities of Bacteria in Vermicasts
4. Conclusions
Author Contributions
Funding
Institutional Review Board Statement
Informed Consent Statement
Data Availability Statement
Acknowledgments
Conflicts of Interest
References
- Byzov, B.A.; Nechitaylo, T.Y.; Bumazhkin, B.K.; Kurakov, A.V.; Golyshin, P.N.; Zvyagintsev, D.G. Culturable microorganisms from the earthworm digestive tract. Microbiology 2009, 78, 360–368. [Google Scholar] [CrossRef]
- Nechitaylo, T.Y.; Yakimov, M.M.; Godinho, M.; Timmis, K.N.; Belogolova, E.; Byzov, B.A.; Kurakov, A.V.; Jones, D.L.; Golyshin, P.N. Effect of the earthworms Lumbricus terrestris and Aporrectodea caliginosa on bacterial diversity in soil. Microb. Ecol. 2010, 59, 574–587. [Google Scholar] [CrossRef] [PubMed]
- Scheu, S. Microbial activity and nutrient dynamics in earthworm casts (Lumbricidae). Biol. Fertil. Soils 1987, 5, 230–234. [Google Scholar] [CrossRef]
- de Menezes, A.B.; Prendergast-Miller, M.T.; Macdonald, L.M.; Toscas, P.; Baker, G.; Farrell, M.; Wark, T.; Richardson, A.E.; Thrall, P.H. Earthworm-induced shifts in microbial diversity in soils with rare versus established invasive earthworm populations. FEMS Microbiol. Ecol. 2018, 94, fiy051. [Google Scholar] [CrossRef] [PubMed]
- Aira, M.; Bybee, S.; Pérez-Losada, M.; Domínguez, J. Feeding on microbiomes: Effects of detritivory on the taxonomic and phylogenetic bacterial composition of animal manures. FEMS Microbiol. Ecol. 2015, 91, fiv117. [Google Scholar] [CrossRef]
- Alauzet, N.; Roussos, S.; Garreau, H.; Vert, M. Microflora dynamics in earthworms casts in an artificial soil (biosynthesol) containing lactic acid oligomers. Braz. Arch. Biol. Technol. 2001, 44, 113–119. [Google Scholar] [CrossRef]
- Dominguez, J.; Edwards, C.A.; Dominguez, J. The biology and population dynamics of Eudrilus eugeniae (Kinberg)(Oligochaeta) in cattle waste solids. Pedobiologia 2001, 45, 341–353. [Google Scholar] [CrossRef]
- Gómez-Brandón, M.; Aira, M.; Lores, M.; Domínguez, J. Epigeic earthworms exert a bottleneck effect on microbial communities through gut associated processes. PLoS ONE 2011, 6, e24786. [Google Scholar] [CrossRef]
- Emperor, G.N.; Kumar, K. Microbial population and activity on vermicompost of Eudrilus eugeniae and Eisenia fetida in different concentrations of tea waste with cow dung and kitchen waste mixture. Int. J. Curr. Microbiol. Appl. Sci. 2015, 4, 497–506. [Google Scholar]
- Yami, K.D.; Bhattarai, S.; Adhikari, S. Vermicomposting and micro flora analysis of vermicompost, vermicast and gut of red earthworm. Nepal J. Sci. Technol. 2003, 5, 121–126. [Google Scholar]
- Idowu, A.B.; Edema, M.O.; Adeyi, A.O. Distribution of bacteria and fungi in the earthworm Libyodrillus violaceous (Annelida: Oligochaeta), a native earthworm from Nigeria. Rev. Biol. Trop. 2006, 54, 49–58. [Google Scholar] [CrossRef] [PubMed]
- Singleton, D.R.; Hendrix, P.F.; Coleman, D.C.; Whitman, W.B. Identification of uncultured bacteria tightly associated with the intestine of the earthworm Lumbricus rubellus (Lumbricidae; Oligochaeta). Soil Biol. Biochem. 2003, 35, 1547–1555. [Google Scholar] [CrossRef]
- Chowdhury, A.; Hazra, A.K.; Mahajan, S.; Choudhury, J. Microbial communities of earthworm (Perionyx excavatus Perrier) gut, cast and adjacent soil in two different fields of west Bengal. Rec. Zool. Surv. India 2007, 107, 101–113. [Google Scholar] [CrossRef]
- Mba, C.C. Rock phosphate solubilizing and cellulolytic actinomycete isolates of earthworm casts. Environ. Manag. 1994, 18, 257–261. [Google Scholar] [CrossRef]
- Dedeke, G.A.; Babatunde, O.; Aladesida, A.A. Earthworm cast biomass under three managed ecosystems: Implication for soil fertility. Ethiop. J. Environ. Stud. Manag. 2015, 8, 464–470. [Google Scholar] [CrossRef]
- Hmar, L.; Ramanujam, S.N. Earthworm cast production and physico-chemical properties in two agroforestry systems of Mizoram (India). Trop. Ecol. 2014, 55, 75–84. [Google Scholar]
- Jouquet, P.; Bottinelli, N.; Podwojewski, P.; Hallaire, V.; Tran Duc, T. Chemical and physical properties of earthworm casts as compared to bulk soil under a range of different land-use systems in Vietnam. Geoderma 2008, 146, 231–238. [Google Scholar] [CrossRef]
- Oyedele, D.J.; Schjønning, P.; Amusan, A.A. Physicochemical properties of earthworm casts and uningested parent soil from selected sites in southwestern Nigeria. Ecol. Eng. 2006, 28, 106–113. [Google Scholar] [CrossRef]
- Kizilkaya, R.; Hepşen, Ş. Microbiological properties in earthworm cast and surrounding soil amended with various organic wastes. Commun. Soil Sci. Plant Anal. 2007, 38, 2861–2876. [Google Scholar] [CrossRef]
- Dedeke, G.A.; Omemu, O.; Aladesida, A.A.; Museliu, F. Comparative microbial analysis of earthworm casts collected from Ikenne, Ogun state, Nigeria. Ethiop. J. Environ. Stud. Manag. 2010, 3, 57–63. [Google Scholar] [CrossRef]
- Chaoui, H.I.; Zibilske, L.M.; Ohno, T. Effects of earthworm casts and compost on soil microbial activity and plant nutrient availability. Soil Biol. Biochem. 2003, 35, 295–302. [Google Scholar] [CrossRef]
- Arancon, N.Q.; Edwards, C.A.; Bierman, P.; Welch, C.; Metzger, J.D. Influences of vermicomposts on field strawberries: 1. Effects on growth and yields. Bioresour. Technol. 2004, 93, 145–153. [Google Scholar] [CrossRef] [PubMed]
- Arancon, N.Q.; Edwards, C.A.; Bierman, P.; Metzger, J.D.; Lucht, C. Effects of vermicomposts produced from cattle manure, food waste and paper waste on the growth and yield of peppers in the field. Pedobiologia 2005, 49, 297–306. [Google Scholar] [CrossRef]
- Atiyeh, R.M.; Subler, S.; Edwards, C.A.; Bachman, G.; Metzger, J.D.; Shuster, W. Effects of vermicomposts and composts on plant growth in horticultural container media and soil. Pedobiologia 2000, 44, 579–590. [Google Scholar] [CrossRef]
- Azarmi, R.; Ziveh, P.S.; Satari, M.R. Effect of vermicompost on growth, yield and nutrition status of tomato (Lycopersicum esculentum). Pak. J. Biol. Sci. 2008, 11, 1797–1802. [Google Scholar] [CrossRef] [PubMed]
- Karmegam, N.; Daniel, T. Effect of application of vermicasts as layering media for an ornamental plant Codiaeum variegatum (L.) Bl. Dyn. Soil Dyn. Plant 2009, 3, 100–104. [Google Scholar]
- Rekha, G.S.; Kaleena, P.K.; Elumalai, D.; Srikumaran, M.P.; Maheswari, V.N. Effects of vermicompost and plant growth enhancers on the exo-morphological features of Capsicum annum (Linn.) Hepper. Int. J. Recycl. Org. Waste Agric. 2018, 7, 83–88. [Google Scholar] [CrossRef]
- Zhao, H.T.; Li, T.P.; Zhang, Y.; Hu, J.; Bai, Y.C.; Shan, Y.H.; Ke, F. Effects of vermicompost amendment as a basal fertilizer on soil properties and cucumber yield and quality under continuous cropping conditions in a greenhouse. J. Soils Sediments 2017, 17, 2718–2730. [Google Scholar] [CrossRef]
- Blakemore, R.J. Eco-taxonomic profile of an iconic vermicomposter—The ‘African nightcrawler’ earthworm, Eudrilus eugeniae (Kinberg, 1867). Afr. Invertebr. 2015, 56, 527–548. [Google Scholar] [CrossRef]
- Guerrero, R.D., III. Vermicomposting gets high marks in the tropics. BioCycle 2005, 46, 60–62. [Google Scholar]
- Guerrero, R.D., III; Guerrero, L.A. Production of vermicompost and earthworm biomass (Eudrilus eugeniae) for organic Nile tilapia (Oreochromis niloticus) culture in freshwater ponds. J. Fish. Aquac. 2014, 5, 154–157. [Google Scholar]
- Owa, S.O.; Olowoparija, S.B.; Aladesida, A.; Dedeke, G.A. Enteric bacteria and fungi of the Eudrilid earthworm Libyodrilus violaceus. Afr. J. Agric. Res. 2013, 8, 1760–1766. [Google Scholar] [CrossRef]
- Bityutskii, N.P.; Kaidun, P.I. The influence of earthworms on the mobility of microelements in soil and their availability for plants. Eurasian Soil Sci. 2008, 41, 1306–1313. [Google Scholar] [CrossRef]
- Aspe, N.M.; Manasan, R.E.; Manlavi, A.B.; Patiluna, M.L.E.; Sebido, M.A.B.; Obusan, M.C.M.; Simbahan, J.F.; James, S.W. The earthworm fauna of Palawan, Philippines with description of nineteen new pheretimoid species (Clitellata: Megascolecidae). J. Nat. Hist. 2021, 55, 733–797. [Google Scholar] [CrossRef]
- Aspe, N.M.; Obusan, M.C.M. Pheretimoid earthworms (Clitellata: Megascolecidae) cultivated in a vermifacility in Los Baños, Laguna, Philippines, with description of a new species. Zootaxa 2023, 5255, 101–112. [Google Scholar] [CrossRef]
- Mathipi, V.; De Mandal, S.; Chawngthu, Z.; Lalfelpuii, R.; Kumar, N.S.; Lalthanzara, H. Diversity and metabolic potential of earthworm gut microbiota in Indo-Myanmar biodiversity hotspot. J. Pure Appl. Microbiol. 2020, 14, 1503–1511. [Google Scholar] [CrossRef]
- Sapkota, R.; Santos, S.; Farias, P.; Krogh, P.H.; Winding, A. Insights into the earthworm gut multi-kingdom microbial communities. Sci. Total Environ. 2020, 727, 138301. [Google Scholar] [CrossRef]
- Frąc, M.; Oszust, K.; Lipiec, J. Community level physiological profiles (CLPP), characterization and microbial activity of soil amended with dairy sewage sludge. Sensors 2012, 12, 3253–3268. [Google Scholar] [CrossRef]
- Denier, J.; Faucon, M.P.; Dulaurent, A.M.; Guidet, J.; Kervroëdan, L.; Lamerre, J.; Houben, D. Earthworm communities and microbial metabolic activity and diversity under conventional, feed and biogas cropping systems as affected by tillage practices. Appl. Soil Ecol. 2022, 169, 104232. [Google Scholar] [CrossRef]
- Pot, S.; De Tender, C.; Ommeslag, S.; Delcour, I.; Ceusters, J.; Gorrens, E.; Debode, J.; Vandecasteele, B.; Vancampenhout, K. Understanding the shift in the microbiome of composts that are optimized for a better fit-for-purpose in growing media. Front. Microbiol. 2021, 12, 643679. [Google Scholar] [CrossRef]
- Wei, Z.; Wang, H.; Ma, C.; Li, S.; Wu, H.; Yuan, K.; Meng, X.; Song, Z.; Fang, X.; Zhao, Z. Unraveling the impact of long-term rice monoculture practice on soil fertility in a rice-planting meadow soil: A perspective from microbial biomass and carbon metabolic rate. Microorganisms 2022, 10, 2153. [Google Scholar] [CrossRef]
- Mudziwapasi, R.; Mlambo, S.S.; Chigu, N.L.; Kuipa, P.K.; Sanyika, W.T. Isolation and molecular characterization of bacteria from the gut of Eisenia fetida for biodegradation of 4,4 DDT. J. Appl. Biol. Biotechnol. 2016, 4, 41–47. [Google Scholar] [CrossRef]
- Bamidele, J.A.; Idowu, A.B.; Ademolu, K.O.; Atayese, A.O. Microbial diversity and digestive enzyme activities in the gut of earthworms found in sawmill industries in Abeokuta, Nigeria. Rev. Biol. Trop. 2014, 62, 1241–1249. [Google Scholar] [CrossRef]
- Gothwal, R.K.; Nigam, V.K.; Mohan, M.K.; Sasmal, D.; Ghosh, P. Screening of nitrogen fixers from rhizospheric bacterial isolates associated with important desert plants. Appl. Ecol. Environ. Res. 2008, 6, 101–109. [Google Scholar] [CrossRef]
- Saiyad, S.A.; Jhala, Y.K.; Vyas, R.V. Comparative efficiency of five potash and phosphate solubilizing bacteria and their key enzymes useful for enhancing and improvement of soil fertility. Int. J. Sci. Res. Publ. 2015, 5, 1–6. [Google Scholar]
- Shanware, A.S.; Kalkar, S.A.; Trivedi, M.M. Potassium solubilisers: Occurrence, mechanism and their role as competent biofertilizers. Int. J. Curr. Microbiol. Appl. Sci. 2014, 3, 622–629. [Google Scholar]
- Sharon, J.A.; Hathwaik, L.T.; Glenn, G.M.; Imam, S.H.; Lee, C.C. Isolation of efficient phosphate solubilizing bacteria capable of enhancing tomato plant growth. J. Soil Sci. Plant Nutr. 2016, 16, 525–536. [Google Scholar] [CrossRef]
- Gryta, A.; Frąc, M.; Oszust, K. The application of the Biolog EcoPlate approach in ecotoxicological evaluation of dairy sewage sludge. Appl. Biochem. Biotechnol. 2014, 174, 1434–1443. [Google Scholar] [CrossRef] [PubMed]
- Muñiz, S.; Lacarta, J.; Pata, M.P.; Jiménez, J.J.; Navarro, E. Analysis of the diversity of substrate utilisation of soil bacteria exposed to Cd and earthworm activity using generalised additive models. PLoS ONE 2014, 9, e85057. [Google Scholar] [CrossRef] [PubMed]
- Lipiec, J.; Frąc, M.; Brzezińska, M.; Turski, M.; Oszust, K. Linking microbial enzymatic activities and functional diversity of soil around earthworm burrows and casts. Front. Microbiol. 2016, 7, 1361. [Google Scholar] [CrossRef]
- Mapile, M.R.F.; Obusan, M.C.M. Mineralization, biodegradation, and antagonistic activities of gut-associated bacteria and fungi of African nightcrawler Eudrilus eugeniae (Kinberg, 1867). Sci. Diliman 2020, 32, 42–67. [Google Scholar]
- Crumsey, J.M.; Le Moine, J.M.; Vogel, C.S.; Nadelhoffer, K.J. Historical patterns of exotic earthworm distributions inform contemporary associations with soil physical and chemical factors across a northern temperate forest. Soil Biol. Biochem. 2014, 68, 503–514. [Google Scholar] [CrossRef]
- Jouquet, P.; Thi, P.N.; Hong, H.N.; Henry-des-Tureaux, T.; Chevallier, T.; Tran Duc, T. Laboratory investigation of organic matter mineralization and nutrient leaching from earthworm casts produced by Amynthas khami. Appl. Soil Ecol. 2011, 47, 24–30. [Google Scholar] [CrossRef]
- Parle, J.N. A microbiological study of earthworm casts. J. Gen. Microbiol. 1963, 31, 13–22. [Google Scholar] [CrossRef]
- Mba, C.C. Rock phosphate solubilizing Streptosporangium isolates from casts of tropical earthworms. Soil Biol. Biochem. 1997, 29, 381–385. [Google Scholar] [CrossRef]
- Krishnamoorthy, R.V. Mineralization of phosphorus by faecal phosphatases of some earthworms of Indian tropics. Anim. Sci. 1990, 99, 509–518. [Google Scholar] [CrossRef]
- Suthar, S. Bioremediation of aerobically treated distillery sludge mixed with cow dung by using an epigeic earthworm Eisenia fetida. Environmentalist 2008, 28, 76–84. [Google Scholar] [CrossRef]
- Atiyeh, R.M.; Domínguez, J.; Subler, S.; Edwards, C.A. Changes in biochemical properties of cow manure during processing by earthworms (Eisenia andrei, Bouché) and the effects on seedling growth. Pedobiologia 2000, 44, 709–724. [Google Scholar] [CrossRef]
- Edwards, C.A.; Dominguez, J.; Arancon, N.Q. The influence of vermicompost on plant growth and pest incidence. In Soil Zoology for Sustainable Development in the 21st Century; Shakir, S.H., Mikhal, W.Z.A., Eds.; IUCN: Cairo, Egypt, 2004; pp. 397–420. [Google Scholar]
- Ferreras, L.; Gómez, E.; Toresani, S.; Firpo, I.; Rotondo, R. Effect of organic amendments on some physical, chemical and biological properties in a horticultural soil. Bioresour. Technol. 2006, 97, 635–640. [Google Scholar] [CrossRef]
- Hidalgo, P.R.; Matta, F.B.; Harkess, R.L. Physical and chemical properties of substrates containing earthworm castings and effects on marigold growth. HortScience 2006, 41, 1474–1476. [Google Scholar] [CrossRef]
- Hidalgo, P.R.; Harkess, R.L. Earthworm castings as a substrate amendment for chrysanthemum production. Hortscience 2002, 37, 1035–1039. [Google Scholar] [CrossRef]
- De la Vega, A. Vermicomposting: The Future of Sustainable Agriculture and Organic Waste Management. Lessons from the USA and Cuba; Royal Horticultural Society: London, UK, 2016; pp. 1–48. [Google Scholar]
- Honeker, L.K.; Gullo, C.F.; Neilson, J.W.; Chorover, J.; Maier, R.M. Effect of re-acidification on buffalo grass rhizosphere and bulk microbial communities during phytostabilization of metalliferous mine tailings. Front. Microbiol. 2019, 10, 1209. [Google Scholar] [CrossRef] [PubMed]
- Proença, D.N.; Whitman, W.B.; Varghese, N.; Shapiro, N.; Woyke, T.; Kyrpides, N.C.; Morais, P.V. Arboriscoccus pini gen. nov., sp. nov., an endophyte from a pine tree of the class Alphaproteobacteria, emended description of Geminicoccus roseus, and proposal of Geminicoccaceae fam. nov. Syst. Appl. Microbiol. 2018, 41, 94–100. [Google Scholar] [CrossRef]
- Chen, X.; Marszałkowska, M.; Reinhold-Hurek, B. Jasmonic acid, not salicyclic acid restricts endophytic root colonization of rice. Front. Plant Sci. 2020, 10, 1758. [Google Scholar] [CrossRef] [PubMed]
- Faoro, H.; Rene Menegazzo, R.; Battistoni, F.; Gyaneshwar, P.; do Amaral, F.P.; Taulé, C.; Rausch, S.; Galvão, P.G.; de los Santos, C.; Mitra, S.; et al. The oil-contaminated soil diazotroph Azoarcus olearius DQS-4T is genetically and phenotypically similar to the model grass endophyte Azoarcus sp. BH72. Environ. Microbiol. Rep. 2017, 9, 223–238. [Google Scholar] [CrossRef]
- Pankievicz, V.C.S.; do Amaral, F.P.; Ané, J.M.; Stacey, G. Diazotrophic bacteria and their mechanisms to interact and benefit cereals. Mol. Plant Microbe Interact. 2021, 34, 491–498. [Google Scholar] [CrossRef]
- Grönemeyer, J.L.; Bünger, W.; Reinhold-Hurek, B. Bradyrhizobium namibiense sp. nov., a symbiotic nitrogen-fixing bacterium from root nodules of Lablab purpureus, hyacinth bean, in Namibia. Int. J. Syst. Evol. Microbiol. 2017, 67, 4884–4891. [Google Scholar] [CrossRef]
- Munakata, Y.; Spina, R.; Slezack-Deschaumes, S.; Genestier, J.; Hehn, A.; Laurain-Mattar, D. Screening of endophytic bacteria of Leucojum aestivum ‘gravety giant’ as a potential source of alkaloids and as antagonist to some plant fungal pathogens. Microorganisms 2022, 10, 2089. [Google Scholar] [CrossRef]
- Muratova, A.; Golubev, S.; Romanova, V.; Sungurtseva, I.; Nurzhanova, A. Effect of heavy-metal-resistant PGPR inoculants on growth, rhizosphere microbiome and remediation potential of Miscanthus × giganteus in zinc-contaminated soil. Microorganisms 2023, 11, 1516. [Google Scholar] [CrossRef]
- Choi, A.; Cha, I.T.; Lee, K.E.; Son, Y.K.; Yu, J.; Seol, D. The role of Flavobacterium enshiense R6S-5-6 in the wetland ecosystem revealed by whole-genome analysis. Curr. Microbiol. 2023, 80, 83. [Google Scholar] [CrossRef]
- Nouioui, I.; del Carmen Montero-Calasanz, M.; Ghodhbane-Gtari, F.; Rohde, M.; Tisa, L.S.; Klenk, H.P.; Gtari, M. Frankia discariae sp. nov.: An infective and effective microsymbiont isolated from the root nodule of Discaria trinervis. Arch. Microbiol. 2017, 199, 641–647. [Google Scholar] [CrossRef] [PubMed]
- Viulu, S.; Nakamura, K.; Okada, Y.; Saitou, S.; Takamizawa, K. Geobacter luticola sp. nov., an Fe (III)-reducing bacterium isolated from lotus field mud. Int. J. Syst. Evol. Microbiol. 2013, 63, 442–448. [Google Scholar] [CrossRef] [PubMed]
- Fan, M.C.; Guo, Y.Q.; Zhang, L.P.; Zhu, Y.M.; Chen, W.M.; Lin, Y.B.; Wei, G.H. Herbaspirillum robiniae sp. nov., isolated from root nodules of Robinia pseudoacacia in a lead–zinc mine. Int. J. Syst. Evol. Microbiol. 2018, 68, 1300–1306. [Google Scholar] [CrossRef] [PubMed]
- Nordstedt, N.P.; Jones, M.L. Isolation of rhizosphere bacteria that improve quality and water stress tolerance in greenhouse ornamentals. Front. Plant Sci. 2020, 11, 826. [Google Scholar] [CrossRef]
- Tapia-García, E.Y.; Hernández-Trejo, V.; Guevara-Luna, J.; Rojas-Rojas, F.U.; Arroyo-Herrera, I.; Meza-Radilla, G.; Vasquez-Murrieta, M.S.; Estrada-de Los Santos, P. Plant growth-promoting bacteria isolated from wild legume nodules and nodules of Phaseolus vulgaris L. trap plants in central and southern Mexico. Microbiol. Res. 2020, 239, 126522. [Google Scholar] [CrossRef]
- Yoneda, Y.; Yamamoto, K.; Makino, A.; Tanaka, Y.; Meng, X.Y.; Hashimoto, J.; Shin-ya, K.; Satoh, N.; Fujie, M.; Toyama, T.; et al. Novel plant-associated acidobacteria promotes growth of common floating aquatic plants, duckweeds. Microorganisms 2021, 9, 1133. [Google Scholar] [CrossRef]
- Bao, Z.; Okubo, T.; Kubota, K.; Kasahara, Y.; Tsurumaru, H.; Anda, M.; Ikeda, S.; Minamisawa, K. Metaproteomic identification of diazotrophic methanotrophs and their localization in root tissues of field-grown rice plants. Appl. Environ. Microbiol. 2014, 80, 5043–5052. [Google Scholar] [CrossRef]
- Chen, Y.; Sun, R.; Sun, T.; Liang, Y.; Jiang, Y.; Sun, B. Organic amendments shift the phosphorus-correlated microbial co-occurrence pattern in the peanut rhizosphere network during long-term fertilization regimes. Appl. Soil Ecol. 2018, 124, 229–239. [Google Scholar] [CrossRef]
- Yamamoto, K.; Shiwa, Y.; Ishige, T.; Sakamoto, H.; Tanaka, K.; Uchino, M.; Tanaka, N.; Oguri, S.; Saitoh, H.; Tsushima, S. Bacterial diversity associated with the rhizosphere and endosphere of two halophytes: Glaux maritima and Salicornia europaea. Front. Microbiol. 2018, 9, 2878. [Google Scholar] [CrossRef]
- Yu, Z.; Chang, M.; Wu, M.; Yang, G.; Zhou, S.; Zhuang, L. Pseudomonas oryzae sp. nov. isolated from a paddy soil in South China. Arch. Microbiol. 2013, 195, 815–822. [Google Scholar] [CrossRef]
- Morvan, S.; Paré, M.C.; Schmitt, A.; Lafond, J.; Hijri, M. Limited effect of thermal pruning on wild blueberry crop and its root-associated microbiota. Front. Plant Sci. 2022, 13, 954935. [Google Scholar] [CrossRef] [PubMed]
- Oberhofer, M.; Hess, J.; Leutgeb, M.; Gössnitzer, F.; Rattei, T.; Wawrosch, C.; Zotchev, S.B. Exploring actinobacteria associated with rhizosphere and endosphere of the native alpine medicinal plant Leontopodium nivale subspecies alpinum. Front. Microbiol. 2019, 10, 2531. [Google Scholar] [CrossRef] [PubMed]
- Chee-Sanford, J.C.; Frost, J.W.; Fries, M.R.; Zhou, J.; Tiedje, J.M. Evidence for acetyl coenzyme A and cinnamoyl coenzyme A in the anaerobic toluene mineralization pathway in Azoarcus tolulyticus Tol-4. Appl. Environ. Microbiol. 1996, 62, 964–973. [Google Scholar] [CrossRef] [PubMed]
- Rabus, R.; Wöhlbrand, L.; Thies, D.; Meyer, M.; Reinhold-Hurek, B.; Kämpfer, P. Aromatoleum gen. nov., a novel genus accommodating the phylogenetic lineage including Azoarcus evansii and related species, and proposal of Aromatoleum aromaticum sp. nov., Aromatoleum petrolei sp. nov., Aromatoleum bremense sp. nov., Aromatoleum toluolicum sp. nov. and Aromatoleum diolicum sp. nov. Int. J. Syst. Evol. Microbiol. 2019, 69, 982–997. [Google Scholar] [CrossRef]
- Zhou, J.; Fries, M.R.; Chee-Sanford, J.C.; Tiedje, J.M. Phylogenetic analyses of a new group of denitrifiers capable of anaerobic growth on toluene and description of Azoarcus tolulyticus sp. nov. Int. J. Syst. Evol. Microbiol. 1995, 45, 500–506. [Google Scholar] [CrossRef]
- Takeda, M.; Kamagata, Y.; Ghiorse, W.C.; Hanada, S.; Koizumi, J.I. Caldimonas manganoxidans gen. nov., sp. nov., a poly (3-hydroxybutyrate)-degrading, manganese-oxidizing thermophile. Int. J. Syst. Evol. Microbiol. 2002, 52, 895–900. [Google Scholar] [CrossRef]
- Mistry, A.N.; Kachenchart, B.; Wongthanaroj, A.; Somwangthanaroj, A.; Luepromchai, E. Rapid biodegradation of high molecular weight semi-crystalline polylactic acid at ambient temperature via enzymatic and alkaline hydrolysis by a defined bacterial consortium. Polym. Degrad. Stab. 2022, 202, 110051. [Google Scholar] [CrossRef]
- Mistry, A.N.; Kachenchart, B.; Pinyakong, O.; Assavalapsakul, W.; Jitpraphai, S.M.; Somwangthanaroj, A.; Luepromchai, E. Bioaugmentation with a defined bacterial consortium: A key to degrade high molecular weight polylactic acid during traditional composting. Bioresour. Technol. 2023, 367, 128237. [Google Scholar] [CrossRef]
- Taş, N.; Van Eekert, M.H.; De Vos, W.M.; Smidt, H. The little bacteria that can–diversity, genomics and ecophysiology of ‘Dehalococcoides’ spp. in contaminated environments. Microb. Biotechnol. 2010, 3, 389–402. [Google Scholar] [CrossRef]
- Papassiopi, N.; Vaxevanidou, K.; Paspaliaris, I. Investigating the use of iron reducing bacteria for the removal of arsenic from contaminated soils. Water Air Soil Pollut. 2003, 3, 81–90. [Google Scholar] [CrossRef]
- Vaxevanidou, K.; Christou, C.; Kremmydas, G.F.; Georgakopoulos, D.G.; Papassiopi, N. Role of indigenous arsenate and iron (III) respiring microorganisms in controlling the mobilization of arsenic in a contaminated soil sample. Bull. Environ. Contam. Toxicol. 2015, 94, 282–288. [Google Scholar] [CrossRef] [PubMed]
- Yoon, M.H.; Im, W.T. Flavisolibacter ginsengiterrae gen. nov., sp. nov. and Flavisolibacter ginsengisoli sp. nov., isolated from ginseng cultivating soil. Int. J. Syst. Evol. Microbiol. 2007, 57, 1834–1839. [Google Scholar] [CrossRef] [PubMed]
- Wischgoll, S.; Heintz, D.; Peters, F.; Erxleben, A.; Sarnighausen, E.; Reski, R.; Van Dorsselaer, A.V.; Boll, M. Gene clusters involved in anaerobic benzoate degradation of Geobacter metallireducens. Mol. Microbiol. 2005, 58, 1238–1252. [Google Scholar] [CrossRef] [PubMed]
- He, Y.; Gong, Y.; Su, Y.; Zhang, Y.; Zhou, X. Bioremediation of Cr (VI) contaminated groundwater by Geobacter sulfurreducens: Environmental factors and electron transfer flow studies. Chemosphere 2019, 221, 793–801. [Google Scholar] [CrossRef]
- Tsao, S.; Wei, D.J.; Chang, Y.T.; Lee, J.F. Aerobic biodegradation of microcystin-LR by an indigenous bacterial mixed culture isolated in Taiwan. Int. Biodeterior. Biodegrad. 2017, 124, 101–108. [Google Scholar] [CrossRef]
- Corteselli, E.M.; Aitken, M.D.; Singleton, D.R. Description of Immundisolibacter cernigliae gen. nov., sp. nov., a high-molecular-weight polycyclic aromatic hydrocarbon-degrading bacterium within the class Gammaproteobacteria, and proposal of Immundisolibacterales ord. nov. and Immundisolibacteraceae fam. nov. Int. J. Syst. Evol. Microbiol. 2017, 67, 925–931. [Google Scholar]
- Kane, S.R.; Chakicherla, A.Y.; Chain, P.S.; Schmidt, R.; Shin, M.W.; Legler, T.C.; Scow, K.M.; Larimer, F.W.; Lucas, S.M.; Richardson, P.M.; et al. Whole-genome analysis of the methyl tert-butyl ether-degrading beta-proteobacterium Methylibium petroleiphilum PM1. J. Bacteriol. 2007, 189, 1931–1945. [Google Scholar] [CrossRef]
- Nakatsu, C.H.; Hristova, K.; Hanada, S.; Meng, X.Y.; Hanson, J.R.; Scow, K.M.; Kamagata, Y. Methylibium petroleiphilum gen. nov., sp. nov., a novel methyl tert-butyl ether-degrading methylotroph of the Betaproteobacteria. Int. J. Syst. Evol. Microbiol. 2006, 56, 983–989. [Google Scholar] [CrossRef]
- Schmidt, R.; Battaglia, V.; Scow, K.; Kane, S.; Hristova, K.R. Involvement of a novel enzyme, MdpA, in methyl tert-butyl ether degradation in Methylibium petroleiphilum PM1. Appl. Environ. Microbiol. 2008, 74, 6631–6638. [Google Scholar] [CrossRef]
- Stackebrandt, E.; Verbarg, S.; Frühling, A.; Busse, H.J.; Tindall, B.J. Dissection of the genus Methylibium: Reclassification of Methylibium fulvum as Rhizobacter fulvus comb. nov., Methylibium aquaticum as Piscinibacter aquaticus gen. nov., comb. nov. and Methylibium subsaxonicum as Rivibacter subsaxonicus gen. nov., comb. nov. and emended descriptions of the genera Rhizobacter and Methylibium. Int. J. Syst. Evol. Microbiol. 2009, 59, 2552–2560. [Google Scholar] [CrossRef]
- Hamamura, N.; Page, C.; Long, T.; Semprini, L.; Arp, D.J. Chloroform cometabolism by butane-grown CF8, Pseudomonas butanovora, and Mycobacterium vaccae JOB5 and methane-grown Methylosinus trichosporium OB3b. Appl. Environ. Microbiol. 1997, 63, 3607–3613. [Google Scholar] [CrossRef]
- Urana, R.; Yadav, J.; Panchal, S.; Sharma, P.; Singh, N. Phytoremediation of PAH compounds by microbial communities in sodic soil. Int. J. Phytoremediation 2023, 25, 1501–1509. [Google Scholar] [CrossRef] [PubMed]
- Brereton, N.J.B.; Gonzalez, E.; Desjardins, D.; Labrecque, M.; Pitre, F.E. Co-cropping with three phytoremediation crops influences rhizosphere microbiome community in contaminated soil. Sci. Total Environ. 2020, 711, 135067. [Google Scholar] [CrossRef]
- Nogi, Y.; Yoshizumi, M.; Hamana, K.; Miyazaki, M.; Horikoshi, K. Povalibacter uvarum gen. nov., sp. nov., a polyvinyl-alcohol-degrading bacterium isolated from grapes. Int. J. Syst. Evol. Microbiol. 2014, 64, 2712–2717. [Google Scholar] [CrossRef] [PubMed]
- Brune, A.; Ludwig, W.; Schink, B. Propionivibrio limicola sp. nov., a fermentative bacterium specialized in the degradation of hydroaromatic compounds, reclassification of Propionibacter pelophilus as Propionivibrio pelophilus comb. nov. and amended description of the genus Propionivibrio. Int. J. Syst. Evol. Microbiol. 2002, 52, 441–444. [Google Scholar] [CrossRef] [PubMed]
- Bazzi, W.; Abou Fayad, A.G.; Nasser, A.; Haraoui, L.P.; Dewachi, O.; Abou-Sitta, G.; Nguyen, V.K.; Abara, A.; Karah, N.; Landecker, H.; et al. Heavy metal toxicity in armed conflicts potentiates AMR in A. baumannii by selecting for antibiotic and heavy metal co-resistance mechanisms. Front. Microbiol. 2020, 11, 68. [Google Scholar] [CrossRef]
- Fahrbach, M.; Kuever, J.; Remesch, M.; Huber, B.E.; Kampfer, P.; Dott, W.; Hollender, J. Steroidobacter denitrificans gen. nov., sp. nov., a steroidal hormone-degrading gammaproteobacterium. Int. J. Syst. Evol. Microbiol. 2008, 58, 2215–2223. [Google Scholar] [CrossRef]
- Fahrbach, M.; Krauss, M.; Preiss, A.; Kohler, H.P.E.; Hollender, J. Anaerobic testosterone degradation in Steroidobacter denitrificans–identification of transformation products. Environ. Pollut. 2010, 158, 2572–2581. [Google Scholar] [CrossRef]
- Ahmed, B.; Floc’h, J.B.; Lahrach, Z.; Hijri, M. Phytate and microbial suspension amendments increased soybean growth and shifted microbial community structure. Microorganisms 2021, 9, 1803. [Google Scholar] [CrossRef]
- Oshiki, M.; Fukushima, T.; Kawano, S.; Nakagawa, J. Draft genome sequence of Thiohalobacter thiocyanaticus strain FOKN1, a neutrophilic halophile capable of thiocyanate degradation. Genome Announc. 2017, 5, 10–1128. [Google Scholar] [CrossRef]

| Vermicasts | Total Read Bases (bp) | Total Reads | GC (%) | AT (%) | Q20 (%) | Q30 (%) |
|---|---|---|---|---|---|---|
| P. losbanosensis (PL) | 98,439,040 | 327,040 | 56.576 | 43.42 | 87.442 | 75.061 |
| E. eugeniae (EE) | 60,496,184 | 200,984 | 52.814 | 47.19 | 88.733 | 77.007 |
| Vermicasts | Quality Reads | Observed OTUs | Chao1 | Shannon | Inverse Simpson | Good’s Coverage |
|---|---|---|---|---|---|---|
| P. losbanosensis (PL) | 4734 | 280 | 280.0 | 6.6834 | 0.9806 | 1.0 |
| E. eugeniae (EE) | 6111 | 133 | 133.25 | 4.2816 | 0.8581 | 0.9997 |
Disclaimer/Publisher’s Note: The statements, opinions and data contained in all publications are solely those of the individual author(s) and contributor(s) and not of MDPI and/or the editor(s). MDPI and/or the editor(s) disclaim responsibility for any injury to people or property resulting from any ideas, methods, instructions or products referred to in the content. |
© 2023 by the authors. Licensee MDPI, Basel, Switzerland. This article is an open access article distributed under the terms and conditions of the Creative Commons Attribution (CC BY) license (https://creativecommons.org/licenses/by/4.0/).
Share and Cite
Mapile, M.R.F.; Aspe, N.M.; Obusan, M.C.M. Vermicast Analysis with the Earthworm Species Pheretima losbanosensis (Crassiclitellata: Megascolecidae): Bacterial Profiles for Potential Applications in Agriculture. Appl. Sci. 2023, 13, 10364. https://doi.org/10.3390/app131810364
Mapile MRF, Aspe NM, Obusan MCM. Vermicast Analysis with the Earthworm Species Pheretima losbanosensis (Crassiclitellata: Megascolecidae): Bacterial Profiles for Potential Applications in Agriculture. Applied Sciences. 2023; 13(18):10364. https://doi.org/10.3390/app131810364
Chicago/Turabian StyleMapile, Maria Reynalen F., Nonillon M. Aspe, and Marie Christine M. Obusan. 2023. "Vermicast Analysis with the Earthworm Species Pheretima losbanosensis (Crassiclitellata: Megascolecidae): Bacterial Profiles for Potential Applications in Agriculture" Applied Sciences 13, no. 18: 10364. https://doi.org/10.3390/app131810364
APA StyleMapile, M. R. F., Aspe, N. M., & Obusan, M. C. M. (2023). Vermicast Analysis with the Earthworm Species Pheretima losbanosensis (Crassiclitellata: Megascolecidae): Bacterial Profiles for Potential Applications in Agriculture. Applied Sciences, 13(18), 10364. https://doi.org/10.3390/app131810364






